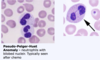

Leukemia Flashcards
(25 cards)
AML - Acute Myelogenous Leukemia
- neoplastic accumulation of __ __ cells (>___%) in the BM
- myeloblasts are usually characterized by +___staining.
- crystal aggregates of MPO may be seen as __ __
Epidemiology:
- commonly arises in ___ __
- 2nd most common cause of cancer in ____
Presentation:
- Anemia –> due to __ __ suppression. ____ accumulate in BM and suppress cell growth of other cells.
- Thrombocytopenia (petechia, bleeding in gums, etc) –> due to __ __
- ____ (infections) –> due to low neutrophils
- WBC count is ___
- enlarged nodes, spleen and liver is___ __ in AML
Diagnosis: Peripheral Blood Smear
- few RBCs and few platelets
- will see presence of ___ and Auer Rods with MPO (note, Auer Rods and MPO can cause ___ if they spill into the plasma)
Markers ___
Risk Factors:
- prior __
- prior ____ ____
- exposure to benzene
- abnormal genetics
Treatment: ____ (7 days) and ____ (days 1-3)
There are three subclassificatons of AML:
1 __
- __
- ___
-
APL Genetics: t(___:____) -___:___
- this involves translocation of ___on Cr. __ to Cr. __
___ disruption blocks maturation and ____ accumulate. This creates a unique treatment plan that is only used in APL –> ___ (all trans-retinoid acid).
Presentation/Markers - Promyelocytes contain lots of ____! They contain numerous primary granules that increased the risk of ___, a common initial presentation.
- These patients already have thrombocytopenia, so if, on top of this, they get __, they become very, very sick.
- So, if a patient as __ and ___ in the blood (+__staining), then you should suspect __
Treatment: __ and ___- triggers promyelocytes to ___ normally. As a result, blasts decrease and WBCs are produced by BM.
2. Acute Monocytic Leukemia
Causes: - proliferation of ___
Markers: - usually ___ ___
Presentation: - blasts characteristically infiltrate ___
3. Acute Megakaryoblastic Leukemia
Causes Proliferation of ___
Markers:
- NO ___
Genetics: - associated with __ __(usually arises after __ yo).
AML may also arise from pre existing dysplasia (__ __), especialy with prior exposure to __ agents or radiotherapy.
MDS Myelodysplasia Syndrome
- ____hematopoiesis - a minor version of AML. Just like AML, MDS is caused by abnormal myeloid progenitor cells, but instead, MDS blast # is __ to ___% (less than ___%)
- Hematopoiesis is suppressed by __ cells in BM, leading to anemia, thrombocytopenia and neutropenia.
Presentation:
- cytopenia
- ____cellular bone marrow
- abnormal maturation of cells,
- blasts cell count - __-___%
Genetics: 5q-MDS - this mutation has better outcomes
Lab Findings: - ___-___ ___
- will see ___ with___ nuclei.
Typically seen after ___
- dysplastic cells on BMB - increased number of blasts (6-19%). Note: MDS can progress to ___ if blast numver progresses to > ___%.
Normal <__% blasts
MDS ___-___% blasts
AML >__% blasts
AML - Acute Myelogenous Leukemia
- neoplastic accumulation of immatuer myelod cells (>20%) in the BM
- myeloblasts are usually characterized by +MPO staining.
- crystal aggregates of MPO may be seen as Auer Rods
Epidemiology: - commonly arises in older adults
- 2nd most common cause of cancer in children
Presentation:
- Anemia –> due to bone marrow suppression. myeloblasts accumulate in BM and suppress cell growth of other cells.
- Thrombocytopenia (petechia, bleeding in gums, etc) –> due to low platelets
- Infections (infections) –> due to low neutrophils
- WBC count is high
- enlarged nodes, spleen and liver is less common in AML
Diagnosis: Peripheral Blood Smear - few RBCs and few platelets - will see presence of blasts and Auer Rods with MPO (note, Auer Rods and MPO can cause DIC if they spill into the plasma)
Markers mpo+
Risk Factors:
- prior chemo
- prior ionizing radiation
- exposure to benzene
- abnormal genetics
Treatment: cytarabine (7 days) and daunorubicin (days 1-3)
There are three subclassificatons of AML:
- APL
- Megakaryoblastic Lekemia
- Monoblastic Leukemia
- APL Genetics: t(15:17) - PML:RAR
- this involves translocation of RAR on Cr. 17 to Cr. 15.
RAR disruption blocks maturation and promyelocytes accumulate. This creates a unique treatment plan that is only used in APL –> ATRA (all trans-retinoid acid).
Presentation/Markers - Promyelocytes contain lots of MPO! They contain numerous primary granules that increased the risk of DIC, a common initial presentation.
- These patients already have thrombocytopenia, so if, on top of this, they get DIC, they become very, very sick.
- So, if a patient as blasts AND DIC in the blood (+MPO staining), then you should suspect APL
Treatment: ATRA and arsenic- triggers promyelocytes to mature normally. As a result, blasts decrease and WBCs are produced by BM.
- Acute Monocytic Leukemia
Causes: - proliferation of monoblasts
Markers: - usually NO MPO
Presentation: - blasts characteristically infiltrate GUMS
- Acute Megakaryoblastic Leukemia
Causes Proliferation of MEGAKARYOBLASTS
Markers:
- NO MPO!
Genetics: - associated with DOWN SYNDROME (usually arises after 5 yo).
AML may also arise from pre existing dysplasia (myelodysplastic syndrome), especialy with prior exposure to alkylating agents or radiotherapy.
MDS Myelodysplasia Syndrome
- ineffectice hematopoiesis - a minor version of AML. Just like AML, MDS is caused by abnormal myeloid progenitor cells, but instead, MDS blast # is 6-19% (less than 20%)
- Hematopoiesis is suppressed by abnormal cells in BM, leading to anemia, thrombocytopenia and neutropenia.
Presentation:
- cytopenia
- hyper cellular bone marrow
- abnormal maturation of cells,
- blasts cell count - 6-19%
Genetics: 5q-MDS - this mutation has better outcomes
Lab Findings: - Pseudo-Pelger-Huet Anomaly - neutrophils with bilobed nuclei.
Typically seen after chemo - dysplastic cells on BMB - increased number of blasts (6-19%). Note: MDS can progress to AML if blast > 20%.
Normal <5% blasts
MDS 6-19% blasts
AML >20% blasts
- *Acute Lymphoblastic Leukemia**
- very common in ____!
- ___ is the second most common leukemia type in children (__ and ___ are rare in children)
- peak age for ALL is __ to ___
- most common initial symptoms of ALL are attributable to ____ (low blood counts) and infiltration of ____ cells into organs
- neoplastic accumulation of ___ (>__%) in the BM
- positive nuclear staining for ____
- increased blasts “__ ___” normal hematopoiesis, resulting in acute presentation with anemia, thrombocytopenia, or neutropenia.
- associated with __ __ and ___ mutation - marrow is ___cellular
Treatment: 6MP
Two Subtypes:
1. B. ALL - most common type of ALL in children (peak incidence 4 yo)
Presentation:
___ –> due to marrow expansion -
____ - due to decreased neutrophils
Lymphadenopathy, splenomegaly, hepatomegaly –> “megaly’s” due to _____ being produced.
- H/A and vomiting –> due to ____ spread of lymphoblast.
- Bone marrow ____ –> due to lymphoblasts overtaking BM leading to anemia, thrombocytopenia, and neutropenia
- *Markers:**
- (____+) that express ___, ___, and ___ (which one is also expressed in burkitt’s and follicular lymphoma?)
Genetics:
- B A.L.L - many different translocations reported, but three are more important:
- ____ t(__:___) translocation
- ___:___ - 20-30% of A.L.L cause in ____!
- 2-3% of A.L.L. cause in children
____ translocation is associated with poor prognosis. ____ creates fusion product of 2 genes. This is commonly seen in ___ and is a ____ prognosis.
- t(12:21) translocation - creates fusion product of 2 genes: ___-____ –> seen mostly in ____
- TEL-AML-1 impairs ____ of blasts and leads to acute leukemia.
B. A.L.L.
Risk Factors: - significantly higher risk in __ __ patients.
- ___ ____ children - risk for ALL is 10-20X greater.
1 - 3% of all ALL cases have __ ___.
Prognosis: ___:____ good prognosis (commonly seen in children)
___:____ worse prognosis (commonly seen in adults)
___ ___ ____ - most power predictor of prognosis - early response to therapy is the single most powerful prognostic predictor
- B.ALL excellent response to chemo, but requires prophylaxis to __ and ___ (sanctuary sites)
T.ALL
T. ALL - characterized by lymphoblasts (___+) that express CD___ to ___. NOT ___.
Presentation:
- usually presents in older aged kids (___ to __ yo) or teenagers (_____>____) as:
- ____ WBC (remember, ___ WBC only seen in leukemias, not lymphomas)
- _____ ____ –> this is due to the thymus, where T cells develop, which makes sense that it would be enlarged
- lymphadenopathy - __ ___ effusion and ___syndrome –> the thymus is an anterior structure, so all mediastinal masses that occur in T.ALL are usually anterior and also associated with pleural effusion.
- ____ obstruction –> b/c tumor can get so large, that it can compress other structures and can cause ____ syndrome (compresses blood flow through SVC).
The patient may presents with difficulty____.
- CNS disease Markers: You will see different markers here than in B. A.L.L. In T.ALL, You will see CD____’s and may also see CD 2, 3, 5, 8, and 4. You will NOT see CD___ (CD___ ONLY FOUND ON PRE-B’S!)
Note: it is called acute lymphoblastic LYMPHOMA because the malignant cells for a mass
CD10 Expressers
Burk’s Balls Fall
Treatment:
- __ ____1 month)
- ____(6-9 months)
- _____ (2-3 years)
- ____treatment (all throughout all above phases)
- *Acute Lymphoblastic Leukemia**
- very common in children!
- AML is the second most common leukemia type in children (CLL and CML are rare in children)
- peak age for ALL is 2-5
- most common initial symptoms of ALL are attributable to cytopenia (low blood counts) and infiltration of lymphoblasts cells into organs
- neoplastic accumulation of lymphoblasts (>20%) in the BM
- positive nuclear staining for Tdt
- increased blasts “disrupt” normal hematopoiesis, resulting in acute presentation with anemia, thrombocytopenia, or neutropenia.
- associated with Down syndrome and IKZF1 mutation - marrow is hypercellular
Treatment: 6MP
Two Subtypes:
1. B. ALL - most common type of ALL in children (peak incidence 4 yo)
Presentation:
bone pain –> due to marrow expansion -
fever- due to decreased neutrophils
Lymphadenopathy, splenomegaly, hepatomegaly –> “megaly’s” due to lymphoblasts being produced.
- H/A and vomiting –> due to meningeal spread of lymphoblast.
- Bone marrow depression –> due to lymphoblasts overtaking BM leading to anemia, thrombocytopenia, and neutropenia
- *Markers:**
- (Tdt+) that express CD19, and CD10 (note: Burkitt’s lymphoma and follicular lymphoma also expresses CD10)
Genetics:
- B A.L.L - many different translocations reported, but three are more important:
-
Philly t(9:22) translocation
* *- 9:22** - 20-30% of A.L.L cause in adults!
- 2-3% of A.L.L. cause in children
9:22 translocation is associated with poor prognosis. 9:22 creates fusion product of 2 genes. This is commonly seen in adults and is a poor prognosis.
- t(12:21) translocation - creates fusion product of 2 genes: TEL-AML–> seen mostly in children
- TEL-AML-1 impairs maturation of blasts and leads to acute leukemia.
B. A.L.L.
Risk Factors: - significantly higher risk in down syndrome patients.
- DS children - risk for ALL is 10-20X greater.
1 - 3% of all ALL cases have DS.
Prognosis: 12:21 good prognosis (commonly seen in children)
9:22 worse prognosis (commonly seen in adults)
MRD (minimal residual disease) - most powerful predictor of prognosis - early response to therapy is the single most powerful prognostic predictor
- B.ALL excellent response to chemo, but requires prophylaxis to CNS and Scrotum (sanctuary sites)
T.ALL
T. ALL - characterized by lymphoblasts (TdT+) that express CD2 to 8. NOT CD10
Presentation:
- usually presents in older aged kids (5 to 12yo) or teenagers (M>F) as:
- HIGH WBC (remember, HIGH WBC only seen in leukemias, not lymphomas)
- MEDIASTINAL MASS –> this is due to the thymus, where T cells develop, which makes sense that it would be enlarged
- lymphadenopathy - ANTERIOR PLEURAL effusion and SVC syndrome –> the thymus is an anterior structure, so all mediastinal masses that occur in T.ALL are usually anterior and also associated with pleural effusion.
- TRACHEAL obstruction –> b/c tumor can get so large, that it can compress other structures and can cause SVC syndrome (compresses blood flow through SVC).
The patient may presents with difficulty BREATHING
- CNS disease Markers: You will see different markers here than in B. A.L.L. In T.ALL, You will see CD7’s and may also see CD 2, 3, 5, 8, and 4. You will NOT see CD10 (CD10 ONLY FOUND ON PRE-B’S!)
Note: it is called acute lymphoblastic LYMPHOMA because the malignant cells for a mass
Treatment:
- REMISSION INDUCTION 1 month)
- CONSOLIDTON (6-9 months)
- MAINTENANCE (2-3 years)
- CNS treatment (all throughout all above phases
CML
- neoplastic proliferation of mature ____ cells, especially _____ and their precursors (___ are characteristically increased)
- ____ total WBC - differential reveals elevated neutrophils, bands, myelocytes, metamyelocytes, eosinophils, basophils and PLATELETS
- will not see an accumulation of ____ in CML like you would see in AMLs.
Genetics: - MUST HAVE ___:___ ___TRANSLOCATION with a breakpoint at ____ which generates __-___ fusion protein which increases __ __ activity.
- when___:___ is always present, the tyrosine kinase is always on –> this provides a constant signal that cause the cell to__.
Cr. __ breakpoints: - p___ (___ kDa protein) = seen in ALL
Presentation of CML: 3 Phases:
- Chronic phase - Myeloid stem cell growing more than normal, but still <___% blast in marrow.
Chronic phase Lab Findings: - increased ____ (WBC = 100,000). - increase neutrophils, basophils and eosinophils.
Note: Remember neutrophil development? Myeloblast –> promyelocytes –> myelocytes –> bands. You can expect all of these to be ____ too.
- few blasts <___%
Chronic Phase Presentation:
- mild anemia, normal or increased platelets. - can be asymptomatic (increased WBCs on testing) - fatigue, malaise, wt. loss, splenomegaly
- <____% BLASTS IN MARROW –> normal .
.after a few years, chronic phase moves to ACCELERATED PHASE:
- Accelerated Phase - treatment failure (rising WBCs), despite therapy. - ___-___% BLASTS IN THE MARROW …accelerated phase will move to ACUTE PHASE
- Acute phase (transformation) - ____ CRISIS –> looks like AML (>____% blasts in periphery or marrow), however, in order to diagnose with CML must have __;___ translocation!
- usually, blasts are ____, so blast crisis is another version of ___.
- Can turn into ___ or ___ transformations: - Can turn into ___ (2/3) or ____ (1/3), since there is a mutation is in a pluripotent stem cell
Differential Diagnosis:
CML or ____ Rxn?
It is very important to distinguish CML from __ __ reaction (Leukomoid reaction), which is a normal response to infection. When you suspect CML, you must rule out the possibility that there is an occult infection going on.
CML must be distinguished from a leukomoid reaction:
- cml granulocytes are LAP ____
- cml is associated with increased ____(UNIQUE!!)
- cml granulocytes exhibit t(___)
LAP: Leukocyte alkaline phosphatase test - an enzyme found in normal ____
LAP - absent in neutrophils of __
- enzyme levels assessed with LAP score:
If: ___ LAP –> CML
If: ____ LAP –> leukomoid reaction
Genetics: 9:22 - BCR-ABL fusion with increased tyrosine kinase activity which leads to long life. This fusion chromosome results in synthesis of tyrosine kinase protein that leads to long cell life –> allows WBCs to evade apoptosis and live a long life. LAP has been largely replaced by testing for Philadelphia chromosome.
Presentation: ___ IS COMMON! - enlarging ___ suggests accereleated phase of disease. - transformation to acute leukemia usually follows shortly thereafter
Treatment: Because CML involves Ph Cr and over expression of __ ___ enzyme, a # of drugs have been developed to target this problem.
- _____ (Gleevec) –> first line tyrosine kinase inhibitor
- Dasatinib
- Nilotinib - these are used for treatment in CML (____ phase) - long term control of disease (not curative)
- bone marrow transplant often used after failure
Other notes: - Gleevec (Imatinib) resistance is developing. - During accelerated phase, use higher doses of ___.
Imatinib binds to ___ on GISTs (GI stromal tumors)
Imatinib binds to ___-alpha, which is seen in ___ ___
CML
- neoplastic proliferation of mature myeloid cells, especially granulocytes and their precursors (BASOPHILS are characteristically increased)
- INCREASED total WBC - differential reveals elevated neutrophils, bands, myelocytes, metamyelocytes, eosinophils, basophils and PLATELETS
- will not see an accumulation of MYELOBLASTS in CML like you would see in AMLs.
Genetics: - MUST HAVE 9:22 PHILLY TRANSLOCATION with a breakpoint at 210 which generates BCR-ABL fusion protein which increases TYROSINE KINASE activity.
- when 9;22 is always present, the tyrosine kinase is always on –> this provides a constant signal that cause the cell to GROW.
Cr. 22 breakpoints: - p190 (190 kDa protein) = seen in ALL
Presentation of CML: 3 Phases:
- Chronic phase - Myeloid stem cell growing more than normal, but still <5% blast in marrow.
Chronic phase Lab Findings: - increased LEUKOCYTOSIS (WBC = 100,000). - increase neutrophils, basophils and eosinophils.
Note: Remember neutrophil development? Myeloblast –> promyelocytes –> myelocytes –> bands. You can expect all of these to be PRESENT too.
- few blasts <5%
Chronic Phase Presentation:
- mild anemia, normal or increased platelets. - can be asymptomatic (increased WBCs on testing) - fatigue, malaise, wt. loss, splenomegaly
- <5% BLASTS IN MARROW –> normal .
.after a few years, chronic phase moves to ACCELERATED PHASE:
- Accelerated Phase - treatment failure (rising WBCs), despite therapy. - 6-19% BLASTS IN THE MARROW …accelerated phase will move to ACUTE PHASE
- Acute phase (transformation) - BLAST CRISIS –> looks like AML (>20% blasts in periphery or marrow), however, in order to diagnose with CML must have 9;22 translocation!
- usually, blasts are MYELOBLAST, so blast crisis is another version of AML
- Can turn into AML or ALL transformations: - Can turn into AML 2/3) or ALL (1/3), since there is a mutation is in a pluripotent stem cell
Differential Diagnosis:
CML or LEUKOMOID Rxn?
It is very important to distinguish CML from LEFT SHIFT reaction (Leukomoid reaction), which is a normal response to infection. When you suspect CML, you must rule out the possibility that there is an occult infection going on.
CML must be distinguished from a leukomoid reaction:
- cml granulocytes are LAP NEGATIVE
- cml is associated with increased BASOPHILS (UNIQUE!!)
- cml granulocytes exhibit t(9;22)
LAP: Leukocyte alkaline phosphatase test - an enzyme found in normal NEUTROPHILS
LAP - absent in neutrophils in CML
- enzyme levels assessed with LAP score:
If: LOW LAP –> CML
If: HIGH LAP –> leukomoid reaction
Genetics: 9:22 - BCR-ABL fusion with increased tyrosine kinase activity which leads to long life. This fusion chromosome results in synthesis of tyrosine kinase protein that leads to long cell life –> allows WBCs to evade apoptosis and live a long life. LAP has been largely replaced by testing for Philadelphia chromosome.
Presentation: SPLENOMEGALY IS COMMON! - enlarging SPLEEN suggests accereleated phase of disease. - transformation to acute leukemia usually follows shortly thereafter
Treatment: Because CML involves Ph Cr and over expression of TYROSINE KINASE enzyme, a # of drugs have been developed to target this problem.
- IMATINIB (Gleevec) –> first line tyrosine kinase inhibitor
- Dasatinib
- Nilotinib - these are used for treatment in CML (CHRONIC phase) - long term control of disease (not curative)
- bone marrow transplant often used after failure
Other notes: - Gleevec (Imatinib) resistance is developing. - During accelerated phase, use higher doses of TKI.
Imatinib binds to C-KIT on GISTs (GI stromal tumors)
Imatinib binds to PDGFR-alpha, which is seen in HYPEREOSINOPHILIC SYNDROME
Chronic Lymphocytic Leukemia - CLL
- neoplastic proliferation of ____ that co express CD___ (unique and also seen in mantle cell and SLL) CD___, CD___, CD___ (+/-) CD___
- most common leukemia overall (C for Common) - but uncommon in ____!
4 STAGES OF CLL
low = 0 - ____ only
intermediate I - lymphocytosis, ____
intermeidiate II - lymphocytosis, ____
High - III - lymphocytosis, with Hb <____ due to progression of CLL in marrow
High IV - lymphocytosis, ___ <__ K due to progression of CLL in marrow
Presentation:
- lymphadenopathy (lymphadenopathy not seen in hairy cell leukemia) –> b/c involvement of lymph nodes
- splenomegaly
- hepatomegaly
Note: when patients are diagnosed, many of them are just observed and go without treatment
Markers: CD_, CD__, CD___, CD___a and CD__ are co-expressed. Unique b/c CD__ = a typical B cell receptor and CD__, typical T cell receptor are expressed together
. Diagnosis: - lots of ___s! SLL is similar to CLL. They have the same malignant cells, but the disorders are differentiated by their WBC count.
____ - lymphocyte < 5000
___ - lymphocyte > 5000
Lab Findings: __ cells!
- Peripheral lymphocytes are fragile and are disrupted during preparation of blood smear
. Epidemiology: - median age of diagnosis is 60
- Pt is often ____.
- CLL often noticed when a pt gets a routine CBC
- physician will notice increased lymphocytes.
- ___-___ % of patients will have___ symptoms (fever, sweats).
Complications: __ __
- ____ –> B cells produce antibodies, so many patients with CLL will develop hypogammaglobulinemia with decreased levels of IgG, IgA, and IgM –> increased susceptibility to bacterial infections!
- ____ –> autoimmune antibodies. These aren’t produced by malignant cells, but from ____ cells. This causes autoimmune hemolytic anemia!
- ___ ____ –> Can transform to diffuse B cell lymphoma (which other lymphoma can do this?) – marked clinically by enlarged spleen or lymph node –> CLL may also transform tissue into large B cell lymphomas
How can we tell if a CLL patient’s thrombocytopenia is from ITP or stage IV disease?
- do a bone marrow biopsy
- In stage IV CLL, you will see ___ platelet count AND absent ____ in BM (b/c CLL has taken over)
- In CLL (not stage IV) and ITP, you will see ___ platelet counts, but you will see ____ in the BM.
Treatment for CLL and ITP- ___
Treatment for stage IV CLL - ___ __ and BM transplant.
Classic presentation: - patient with h/o CLL and suddenly sees rapid growth of ___ ___ lymphoma.
Treatment: bone marrow transplant but only if they have symptoms (stage 3 or 4 … Hb <11 and Plts < 100K)
Chronic Lymphocytic Leukemia - CLL
- neoplastic proliferation of naive B cells that co express CD5 (unique) CD19, CD79a, CD23 (+/-) CD20
- most common leukemia overall (C for Common) - but uncommon in children!
4 STAGES OF CLL
low = 0 - lymphocytosis only
intermediate I - lymphocytosis, lymphadenopathy
intermeidiate II - lymphocytosis, splenomegaly
High - III - lymphocytosis, with Hb <11.0 due to progression of CLL in marrow
High IV - lymphocytosis, platelets <100 K due to progression of CLL in marrow
Presentation:
- lymphadenopathy (lymphadenopathy not seen in hairy cell leukemia) –> b/c involvement of lymph nodes
- splenomegaly
- hepatomegaly
Note: when patients are diagnosed, many of them are just observed and go without treatment
Markers: CD5, CD19, CD20, CD79a and CD23 are co-expressed. Unique b/c CD20 = a typical B cell receptor and CD5, typical T cell receptor are expressed together
. Diagnosis: - lots of WBCss! SLL is similar to CLL. They have the same malignant cells, but the disorders are differentiated by their WBC count.
CLL - lymphocyte < 5000
SLL - lymphocyte > 5000
Lab Findings: smuge cells!
- Peripheral lymphocytes are fragile and are disrupted during preparation of blood smear
. Epidemiology: - median age of diagnosis is 60
- Pt is often asymptomatic
- CLL often noticed when a pt gets a routine CBC
- physician will notice increased lymphocytes.
- 5-10 % of patients will have B symptoms (fever, sweats).
Complications: Immune dysregulation
- Hypogammaglobulinemia –> B cells produce antibodies, so many patients with CLL will develop hypogammaglobulinemia with decreased levels of IgG, IgA, and IgM –> increased susceptibility to bacterial infections!
- AIHA –> autoimmune antibodies. These aren’t produced by malignant cells, but from self cells. This causes autoimmune hemolytic anemia!
- Richter transformation –> Can transform to diffuse B cell lymphoma (like follicular lymphoma)– marked clinically by enlarged spleen or lymph node –> CLL may also transform tissue into large B cell lymphomas
How can we tell if a CLL patient’s thrombocytopenia is from ITP or stage IV disease?
- do a bone marrow biopsy
- In stage IV CLL, you will see low platelet count AND absent megakaryocytes in BM (b/c CLL has taken over)
- In CLL (not stage IV) and ITP, you will see low platelet counts, but you will see megakaryocytes in the BM.
Treatment for CLL and ITP- predisone
Treatment for stage IV CLL - cytotoxic chemo and BM transplant.
Classic presentation: - patient with h/o CLL and suddenly sees rapid growth of B cell lymphoma.
Treatment: bone marrow transplant but only if they have symptoms (stage 3 or 4 … Hb <11 and Plts < 100K)
Hairy Cell Leukemia
- neoplastic proliferation of mature B cells characterized by ___ cytoplasmic processes - comprises ___% of all leukemias
- rare, chronic __ cell lymphoma
- CD____ is the sensitive marker
Epidemiology: - median age is ___
- Presenting feature often ____ pain.
- fatigue, weakness, splenomegaly, bone marrow suppression (anemia, and loss of platelets)
Markers: CD___
Lab Findings: - lymphocytes with ___-like cytoplasmic projections.
Unique features:
- ___ ___ (due to accumulation of hairy cells in red pulp), but no _____ –> red pulp in spleen gets engorged and atrophies/obliterates the white pulp.
- ___ tap on BMB –> b/c hairy cells induce ___.
- ____ staining - Tartrate resistant acid phosphatase is expressed in hairy cells. This is a cellular ___ in hairy cells, so hairy cells have strong ___ for TRAP staining.
Treatment: ____ (2CDA) - preferred initial therapy for HCL. Excellent clinical response. It is similar to adenosine (pure analog) and is highly toxic to cells in HCL.
Hairy Cell Leukemia
- neoplastic proliferation of mature B cells characterized by hairy cytoplasmic processes - comprises 2% of all leukemias
- rare, chronic B cell lymphoma
- CD103 is the sensitive marker
Epidemiology: - median age is 52
- Presenting feature often abdominal pain (B/c of splenomegaly).
- fatigue, weakness, splenomegaly, bone marrow suppression (anemia, and loss of platelets)
Markers: CD103
Lab Findings: - lymphocytes with hair-like cytoplasmic projections.
Unique features:
- massive splenomegaly (due to accumulation of hairy cells in red pulp), but no lymphadenopathy –> red pulp in spleen gets engorged and atrophies/obliterates the white pulp.
- dry tap on BMB –> b/c hairy cells induce fibrosis.
- trap staining - Tartrate resistant acid phosphatase is expressed in hairy cells. This is a cellular enzyme in hairy cells, so hairy cells have strong expression for TRAP staining.
Treatment: cladribine (2CDA) - preferred initial therapy for HCL. Excellent clinical response. It is similar to adenosine (pure analog) and is highly toxic to cells in HCL.

Follicular Lymphoma
- most common low grade non-hodgkin lymphoma -
____% of all new NHL diagnosis
- neoplastic proliferation of __ ___ cells (CD20) that form ___-like nodules
- Usually, expresses CD___ and CD___, and ___-__
- Most cells express surface immunoglobulins - _____ lymphadenopathy
- follicular lymphoma cells consists of ____, the small ____cells, and centro____, larger cells that divide more.
- the larger the number of___, the more aggressive the follicular lymphoma
Epidemiology: - presents in ___
Markers: name 3
___. ___. ___, ___
Presentation:
- _____ lymphadenopathy
- ____ course: __ and ____ for years
- not all patients require___, however, ___ to cure
Genetics: - t(___;____)
- 85% of patients have a translocation of heavy chain Ig (___) to ____ (Cr. 18)
- Causes ____ over expression!
- __ over expression blocks___ (____ is an antagonist of __)
Cr. 14: ___ locus
Cr. 18:____ locus
Differential Diagnosis:
You must be able to distinguish FL from ___ ___ ____!!! The presence of _____ set reactive LAD apart from follicular lymphoma!! LAD and FL both have high ____ growth!
But:
- LAD has high follicular growth due to __ __. There is also varying __ and ___ in these B cells.
There is____ of many B cells as a result and lots of death.
This causes lots of cellular ___ which is cleaned up by ____ –> the presence of ____ set reactive LAD apart from follicular lymphoma. ____ ARE seen in LAD, but not in follicular lymphoma.
- Germinal center B cells usually lack ____.
- Most B cells undergo ____ unless selected by __ ___.
Prognosis: Not___, but is ____.
____ is a feared consequence of follicular lymphoma. Histology transformation occurs ___ to ___% of cases. When this happens, prognosis is ___!
Treatment: - reserved for people who are _____ - if symptomatic, use low dose chemo, or ____ (anti CD____)
Complications: - progression to diffuse large B cell lymphoma
- presents as an enlarging ___ _____ (SAME AS IN HCL)
Follicular Lymphoma
- most common low grade non-hodgkin lymphoma -
22% of all new NHL diagnosis
- neoplastic proliferation of SMALL B CELLS cells (CD20) that form FOLLICULE-like nodules
- Usually, expresses CD10, CD19 and CD20, and BCL-2
- Most cells express surface immunoglobulins - PAINLESS lymphadenopathy
- follicular lymphoma cells consists of CENTROCYTES, the small CLEAVED cells, and centroBLASTS, larger cells that divide more.
- the larger the number of CENTROBLASTS, the more aggressive the follicular lymphoma
Epidemiology: - presents IN ELDERLY
Markers: CD19, CD20, BCL2, CD10
Presentation:
- PAINLESS lymphadenopathy
- INDOLENT course: WAXES and WANES for years
- not all patients require TREATMENT, however, DIFFICULT to cure
Genetics: - t(14;18)
- 85% of patients have a translocation of heavy chain Ig (Cr. 14) to BCL (Cr. 18)
- Causes BCL2 over expression!
- BCL2 over expression blocks APOPTOSIS (BCL2 is an antagonist of CELL DEATH)
Cr. 14: IGH locus
Cr. 18: BCL locus
Differential Diagnosis:
You must be able to distinguish FL from REACTIVE LYMPHADENOPATHY!!! The presence of MACROPHAGES set reactive LAD apart from follicular lymphoma!! LAD and FL both have high FOLLICULAR growth!
But:
- LAD has high follicular growth due to SOMATIC HYPERMUTATION. There is also varying SIZES and SHAPES in these B cells.
There is APOPTOSIS of many B cells as a result and lots of death.
This causes lots of cellular DEBRIS which is cleaned up by MACROPHAGES–> the presence of MACROPHAGES set reactive LAD apart from follicular lymphoma. MACROPHAGES ARE seen in LAD, but not in follicular lymphoma.
- Germinal center B cells usually lack BCL2.
- Most B cells undergo APOPTOSIS unless selected by SOMATIC HYPERMUTATION.
Prognosis: Not CURABLE, but is TREATABLE
DLBCL is a feared consequence of follicular lymphoma. Histology transformation occurs 10 to 70% of cases. When this happens, prognosis is POOR!
Treatment: - reserved for people who are SYMPTOMATIC - if symptomatic, use low dose chemo, or RITUXIMAB (anti CD20)
Complications: - progression to diffuse large B cell lymphoma
- presents as an enlarging PAINLESS LYMPHADENOPATHY
Diffuse Large B Cell (DLBCL)
- Most ___ aggressive NH lymphoma
- Neoplastic ____ ___ __ (CD__)
- Clinically AGGRESSIVE
- occurs in ___. An ____ DEFINING MALIGNANCY
- arises sporadically from transformation of ____ lymphoma OR ___ ___ ____
Epidemiology: - affects usually _____ but affects ___% of children
Genetics: - 30% of patients have a ___;___ translocation
- Alternations in ___ and ____
Markers: - expression of CD___ and CD___
Presentation: - presents late in adulthood as an enlarging LN or ___ ___ mass
Treatment:
Name 5 drugs
Diffuse Large B Cell (DLBCL)
- Most COMMON aggressive NH lymphoma
- Neoplastic LARGE B CELL LYMPHOMA (CD20)
- Clinically AGGRESSIVE
- occurs in HIV. An AIDS DEFINING MALIGNANCY
- arises sporadically from transformation of FOLLICULAR lymphoma or chronic lymphocytic leukemia.
Epidemiology: - affects usually OLDER ADULTS but affects 20% of children
Genetics: - 30% of patients have a 14;18 translocation
- Alternations in BCL2 and BCL6
Markers: - expression of CD19 and CD20
Presentation: - presents late in adulthood as an enlarging LN or EXTRA NODALmass
Treatment:
R-CHOP
Name 5 drugs
RITUXIMAB
CYCLOPHOSPHAMIDE
HYDROXY-DOXORUBICIN
ONCOVIN- VINCRISTINE
PREDNISONE
Burkitt Lymphoma
- Neoplastic of ____ (CD___ and CD__)
- associated with ____ - one of the fastest growing tumors that exist
- doubling time is __ to __ hrs
- Usually express CD___, CD____ and CD__
- VERY ____ –> rapidly proliferative
Epidemiology: - affects adolescents of young adults - ___ form - involves jaw
- Sporadic form - involves ___
Genetics: - t(__;___) translocation - but can also be __;___ translocation or ___;___ translocation.
_____ nuclear regulator) gene is translocated.
lots of ___ –> causes lots of growth!
- ___ gene found on Cr. __.
What is ____? ____ is a growth promoter. Often, it is translocated to Cr. ___ (where ___ B cell heavy chain gene is located).
This translocation leads to over expression of ___ gene on B cells and causes ____.
Diagnosis - need tissue sample (because it is NOT in the blood) - ____% Ki-67 staining (Ki-67 shows us how many cells are ___)
Lab Findings: “__-___” appearance –> numerous rapidly dividing Burkitt Lymphoma cells create lots of ___. This debris is cleared by ____ which create a clearing space. This gives Burkitts Lymphoma a “__ ___” appearance.
Three forms:
1. Endemic -
African and New Guinea
- found in Africa and New Guinea - __-___% of childhood cancer in some regions b/c such a large prevalence of EBV.
- affects children __-__ years old (typically young ___) -
- Commonly presents as a mass in ____ (classic presentation) - tumor cells originate from a single ___-infected B cell so ___ is almost always found.
2. Sporadic - usually what we see in the US
- involves the abdomen, ovaries, kidneys, momentum, extra nodal sites, walldeyers rings.
- also occurs in ___
- This form presents as an ___ mass in ___ OR ____
- Immunodeficiency type
- primarily occurs in patients affected with ___, also seen in ___ recipients, ____ immunodeficiency states
- accounts for__-___% of all NHL in __ pts
Other AIDS defining malignancies:
- ___ sarcoma
- Systemic __
- ___ cancer
Burkitt Lymphoma
- Neoplastic of intermediate sized B cells (CD20 and CD10)
- associated with EBV - one of the fastest growing tumors that exist
- doubling time is 24 to 48 hrs
- Usually express CD10, CD19and CD20
- VERY ____ –> rapidly proliferative
Epidemiology: - affects adolescents of young adults - ENDEMIC form - involves jaw
- Sporadic form - involves ABDOMEN
Genetics: - t(8;14) translocation - but can also be 8;22 translocation or 8;2 translocation.
c-myc nuclear regulator) gene is translocated.
lots of cmyc –> causes lots of growth!
-cmyb gene found on Cr. 8.
What is cmyc? cmycis a growth promoter. Often, it is translocated to Cr. 14 (where Ig B cell heavy chain gene is located).
This translocation leads to over expression of cmyc gene on B cells and causes overgrowth.
Diagnosis - need tissue sample (because it is NOT in the blood) - 100% Ki-67 staining (Ki-67 shows us how many cells are dividing)
Lab Findings: “starry-sky” appearance –> numerous rapidly dividing Burkitt Lymphoma cells create lots of debris. This debris is cleared by macrophages which create a clearing space. This gives Burkitts Lymphoma a “starry sky” appearance.
Three forms:
1. Endemic -
African and New Guinea
- found in Africa and New Guinea - 20-30% of childhood cancer in some regions b/c such a large prevalence of EBV.
- affects children 4-7 years old (typically young boys) -
- Commonly presents as a mass in mandible (classic presentation) - tumor cells originate from a single EBV -infected B cell so EBV is almost always found.
2. Sporadic - usually what we see in the US
- involves the abdomen, ovaries, kidneys, momentum, extra nodal sites, walldeyers rings.
- also occurs in CHILDREN
- This form presents as an ABDOMINAL mass in ILEOCECUM OR PERITONEUM
- Immunodeficiency type
- primarily occurs in patients affected with HIV, also seen in ALLOGRAFT recipients, CONGENITAL immunodeficiency states
- accounts for 30-40% of all NHL in AIDS pts
Other AIDS defining malignancies:
- KAPOSI sarcoma
- Systemic NHL
- CERVICAL cancer
Polycythemia Vera
- neoplastic proliferation of mature myeloid cells, especially ___ ___ cells.
- granulocytes and platelets are also increased Genetics:
- associated with ___ mutation
Hgb: __ (normal 15)
Hct: __ (normal 45)
Presentation: - symptoms mostly due to ___ blood
- blurry ___ and ___ ache
- ___ face (facial ___) due to congestion.
Also, increased RBC leads to increase in blood ____, which causes ___ and ___
- increased risk for venous thrombosis from too many ____ and ____ blood (e.g. hepatic vein, portal vein, dural sinuses).
classically, ___-___ syndrome (blood clot in ___ vein) –> when you get a thrombosis in the hepatic vein which gives infarct in the liver
- ___-____ ____ - an unbearable itching after bathing because lots of ___ cells
- increased plasma___ . Note: many patients ____ (usually discovered after routine CBC) Differential
Diagnosis: PV MUST BE DISTINGUSHED FROM __ ___!
Why? –> if we have increased RBC, that could actually be due to another condition. For example, lets say that someone has lung disease, then their saturation O2 would be ___, and EPO would be ____. -
We could also get reactive PV from topic EPO production from renal cell carcinoma.
- In RCC, EPO is ____ and SaO2 is ___.
BUT…in PV, SaO2 is ____ and EPO is ____ due to ___ ____ b/c so many RBCs*
So, when diagnosing PV, we must exclude:
- ___ from lung disease)
- __ __ ___ (from too much EPO being produced by cancer)
Treatment: - ____ (take away RBCs)
- second line - ___ - inhibits replication of RBC
Note: without treatment, death usually occurs within a year. Complications:
- Spent phase (~15% of patients) - BM gets “burned out” and there is BM ___. This leads to ___
- Leukemia - usually progresses to __ – rarely to ___
- ____ - excess DNA turnover from increased RBC production. This can inrease ____ metabolism using to increased uric acid –> ____. Note that this also happens in ___.
Polycythemia Vera
- neoplastic proliferation of mature myeloid cells, especially RB cells.
- granulocytes and platelets are also increased Genetics:
- associated with JAK2 mutation
Hgb: 20 (normal 15)
Hct: 60 (normal 45)
Presentation: - symptoms mostly due to VISCOUS blood
- blurry VISION and HEADACHE
- FLUSHED face (facial PLETHORA due to congestion.
Also, increased RBC leads to increase in blood VOLUME, which causes HYPERTENSION and THROMNBOSIS
- increased risk for venous thrombosis from too many PLATELETS and VISCOUS blood (e.g. hepatic vein, portal vein, dural sinuses).
classically, BUDD-CHIARI syndrome (blood clot in PORTAL vein) –> when you get a thrombosis in the hepatic vein which gives infarct in the liver
- AQUA-GENIS PRURITIS - an unbearable itching after bathing because lots of MAST cells
- increased plasma VOLUME. Note: many patients ASYMPTOMATIC (usually discovered after routine CBC) Differential
Diagnosis: PV MUST BE DISTINGUSHED FROM REACTIVE POLYCYTHEMIA VERA!
Why? –> if we have increased RBC, that could actually be due to another condition. For example, lets say that someone has lung disease, then their saturation O2 would be LOW , and EPO would be NORMAL. -
We could also get reactive PV from topic EPO production from renal cell carcinoma.
- In RCC, EPO is HIGH and SaO2 is NORMAL
BUT…in PV, SaO2 is NORMAL and EPO is DECREASED due to NEGATIVE FEEDBACK b/c so many RBCs*
So, when diagnosing PV, we must exclude:
- HYPOXIA from lung disease)
- RENAL CELL CARCINOMA (from too much EPO being produced by cancer)
Treatment: - PHLEBOTOMY (take away RBCs)
- second line - HYDROXYUREA - inhibits replication of RBC
Note: without treatment, death usually occurs within a year. Complications:
- Spent phase (~15% of patients) - BM gets “burned out” and there is BM FAILURE. This leads to MYELOFIBROSIS
- Leukemia - usually progresses to AML – rarely to CML
- GOUT - excess DNA turnover from increased RBC production. This can inrease PURINE metabolism using to increased uric acid –> GOUT. Note that this also happens in CML.
Essential Thrombocythemia
- malignant proliferation of ____cells, especially _____
Genetics: - associated with ____ mutation - predominantly affects ____/____
Presentation: - increased risk of ___ and/or ___ –> although there is an ____ in platelet count, they are not functioning properly, so you can still get bleeding or you can get thrombosis. - rarely progresses to marrow ____ or acute leukemia
- no significant risk for ___ OR ____
- abnormal ___ function
Differential Diagnosis: - must exclude other _____ disorders.
In ___ and ___, you can ALSO see higher platelet count so you must rule CML and PV out first. In addition, you must exclude out ___ __. This causes high platelets because of another condition such as in: - infections - metastatic cancer - acute bleeding, hemolysis
Key blood tests: - measure RBC and test for __ __ ___. So, if C-reactive protein, fibrinogen, ESR or ferritin is high, then there could be high platelets due to an occult _____ reaction.
Prognosis: - Most patients have no disease related complications. PV complications are unusual
Treatment: ___, ____
Essential Thrombocythemia
- malignant proliferation of MATURE MYELOID cells, especially MEGAKARYOCYTES
Genetics: - associated with JAK2 mutation - predominantly affects MEGAKARYOCYTES/PLATELETS
Presentation: - increased risk of BLEEDING and/or THROMBOSIS–> although there is an INCREASE in platelet count, they are not functioning properly, so you can still get bleeding or you can get thrombosis. - rarely progresses to marrow FIBROSIS or acute leukemia
- no significant risk for HYPERURECEMIA OR GOUT
- abnormal PLATELET function
Differential Diagnosis: - must exclude other MYELOPROLIFERATIVE disorders.
In CML AND PV, you can ALSO see higher platelet count so you must rule CML and PV out first. In addition, you must exclude out REACTIVE THROMBOCYTHEMIA. This causes high platelets because of another condition such as in: - infections - metastatic cancer - acute bleeding, hemolysis
Key blood tests: - measure RBC and test for ACUTE PHASE REACTANTS. So, if C-reactive protein, fibrinogen, ESR or ferritin is high, then there could be high platelets due to an occult INFLAMMATION reaction.
Prognosis: - Most patients have no disease related complications. PV complications are unusual
Treatment: ASPIRIN, HYDROXYUREA
MYELOFIBROSIS
- neoplastic proliferation of mature myeloid cells, especially _____
Genetics: - associated with __ MUTATION (50% of time)
- excess ____ form fibroblast leads to marrow ___
- ___ overtakes BM causing ___
Growth Factors:____ AND ____
Pathophysiology of primary myelofibrosis
- marrow finding –> __ ___ hematopoiesis.
- when bone marrow fails, organs like the spleen, liver, and lymph nodes to undergo __ ___hematopoiesis - can be seen in CNS, lungs, bladder and even skin!
Epidemiology - affects ___
Presentation - MASSIVE __
- once the bone marrow is ____, hematopoiesis can no longer occur. As a result, stem cells go back to making cells in the ___ AND ___ (like it was in the fetus). But, because there is massive extra hematopoiesis, you will see an ___ spleen.
- fatigue, wt loss and night sweets –> due to increased ____
- __ ___ abdominal pain –> due to ___!
- early ___ (due to ___ ____)
- may also see enlarged lymph nodes - infection, thrombosis, bleeding –> b/c BM can’t properly make red, white and platelet cells.
- Hyperuricemia - ____ –> due to high cell turnover
–> increased metabolism due to extra medullary hematopoiesis b/c BM is nonfunctioning
Lab Findings: - _____ smear - inappropriate release of cells from marrow - you will see immature __ and ___ precursors in blood - ___ ___ CELLS (____) is a CLASSIC finding in myelofibrosis. This is because RBCs are ___ as they squeeze through the fibrosis marrow!!
What is a leukoerythoblastic smear?
- When cells are made in the bone marrow, the BM has ____ gates. These “gates” prevent cells that are immature from exiting in the blood. These gates are made up of reticulin. In the spleen, when extra medullary hematopoiesis occurs, we won’t be able to prevent immature cells from leaving the spleen, so we get ____ cells (increased white, red, and immature cells in blood–we will end up seeing ____ blood cells).
- increased risk of infection, thrombosis and bleeding –> b/c BM can’t properly make red, white and platelet cells.
The vast majority of cell production has shifted over to the ___, however, the spleen is tiny compared to BM, so even though pt undergoes extrahematopoiesis, it is no where where they need to be.
Treamtment:__ __ __
MYELOFIBROSIS
- neoplastic proliferation of mature myeloid cells, especially MEGAKARYOCYTES
Genetics: - associated with JAK2 MUTATION (50% of time)
- excess COLLAGEN form fibroblast leads to marrow FIBROSIS
- COLLAGEN overtakes BM causing FIBROSIS
Growth Factors:PDGF AND TGF-B
Pathophysiology of primary myelofibrosis
- marrow finding –> EXTRA MEDULLARY hematopoiesis.
- when bone marrow fails, organs like the spleen, liver, and lymph nodes to undergo EXTRAMEDULLARY hematopoiesis - can be seen in CNS, lungs, bladder and even skin!
Epidemiology - affects OLDER PEOPLE
Presentation - MASSIVE SPLENOMEGALY
- once the bone marrow is FIBROSED, hematopoiesis can no longer occur. As a result, stem cells go back to making cells in the SPLEEN AND LIVER (like it was in the fetus). But, because there is massive extra hematopoiesis, you will see an ENLARGED spleen.
- fatigue, wt loss and night sweets –> due to increased METABOLISM
- LEFT UPPER abdominal pain –> due to SPLEEN!
- early SATIETY(due to COMPRESSED STOMACH)
- may also see enlarged lymph nodes - infection, thrombosis, bleeding –> b/c BM can’t properly make red, white and platelet cells.
- Hyperuricemia - GOUT –> due to high cell turnover
–> increased metabolism due to extra medullary hematopoiesis b/c BM is nonfunctioning
Lab Findings: - LEUKOERYTHBLASTIC smear - inappropriate release of cells from marrow - you will see immature GRANULOCYTE and RBC precursors in blood - TEAR DROP CELLS (DACROCYTES) is a CLASSIC finding in myelofibrosis. This is because RBCs are DEFORMED as they squeeze through the fibrosis marrow!!
What is a leukoerythoblastic smear?
- When cells are made in the bone marrow, the BM has RETICULATED gates. These “gates” prevent cells that are immature from exiting in the blood. These gates are made up of reticulin. In the spleen, when extra medullary hematopoiesis occurs, we won’t be able to prevent immature cells from leaving the spleen, so we get LEUKOERYTHOBLASTIC cells (increased white, red, and immature cells in blood–we will end up seeing NUCLEATED blood cells).
- increased risk of infection, thrombosis and bleeding –> b/c BM can’t properly make red, white and platelet cells.
The vast majority of cell production has shifted over to the SPLEEN, however, the spleen is tiny compared to BM, so even though pt undergoes extrahematopoiesis, it is no where where they need to be.
Treamtment: STEM CELL REPLACEMENT
Hodgkin Lymphoma
(40%) - neoplastic proliferation of REED STERNBERG CELLS, which are large B cells with multi lobed nuclei and prominent nucleoli “owl eyes”
- classically, POSITIVE FOR CD__AND CD___
- HL spreads in a very ____ manner.
Epidemiology: - HL has a ___ distribution - peaks at __ and __.
Presentation: - Enlarged ___ ___ node (which other disorder shares this feature?)
___ is the key word! __ lymph nodes are seen in infections, and these “reactive” lymph nodes are tender to touch.
So, enlarged painless lymph nodes suggest malignancy such as lymphomas.
- __ __ Cells - secrete __ - CAUSING “___” symptoms
- lymphadenopathy and systemic symptoms caused by __ __ ___ release of ___ (include symptoms like fever, chills, wt. loss, night sweats).
- cytokines attract lymphocyte, plasma cells, Macs and eosinophils (makes up the ___ of the tumor) -
RSC these are large multi lobed cells. Two halves are often mirror images of each other and look like “owl’s eyes.”
- RS cells are usually CD___And CD__ positive! (they are NOT CD19, 20, 21, OR 22 POSITIVE!)
Hodgkin’s Hair Wax was Painless
- attract reactive lymphocytes, plasma cells, macrophages and eosinophils - may lead to ____
(Note: although RS cells are in Hodgkin Lymphoma, they can also be seen in other disorders)
The malignant cell in Hodgkin Lymphoma is the Reed Sternberg cell. The cell is actually a minority in the cells that make up the enlarged lymph node. (only about 1-5%). The bulk of the cells are reacting to the presence of the RS cell’s release of large cytokines. If you remember, RS cells release lots of cytokines too. This can help you to remember that B symptoms are more common in Hodgkin lymphoma than in nonhodgkin lymphoma.
In addition, HL may lead to hyper-____. Why?
- b/c one of the reactive cell types are _____ which have ____, and enzyme which converts __ to ___
Risk Factors: - prior ___ infection (virus infects B cells)
- immunosuppresants
- autoimmune diseases (RA, SLE)
Treatment: chemotherapy and radiation therapy, ___
4 types:
- Nodular sclerosing - most common (70%)
Classical Presentation: - enlarging ___ neck or ___ LN in a ___ adult (usually ___)
Lab Findings: - _____ ____ ___ ___ cells seen in clear __-___ spaces
- Fibrous tissue surrounds a portion of tumor, creating nodules (NS type get its name because of this)
Prognosis: - Slow growth –> indolent - ___ long term survival for the patient
- Mixed Cellularity - associated with abundance of ____ (called in by___ which is produced by ___ __ cells) - will also see eosinophils, neutrophils, macrophages, plasma cells
- Lymphocyte Rich: -___ prognosis
- Lymphocyte poor ; - ___ prognosis
Hodgkin Lymphoma
(40%) - neoplastic proliferation of REED STERNBERG CELLS, which are large B cells with multi lobed nuclei and prominent nucleoli “owl eyes”
- classically, POSITIVE FOR CD15 AND CD30
- HL spreads in a very PREDICTABLE manner.
Epidemiology: - HL has a BIMODAL distribution - peaks at 20 and 60.
Presentation: - Enlarged PAINLESS LYMPH node. this is similar to HCL.
PAINLESS is the key word! PAINFUL lymph nodes are seen in infections, and these “reactive” lymph nodes are tender to touch.
So, enlarged painless lymph nodes suggest malignancy such as lymphomas.
- REED STERNBERG Cells - secrete CYTOKINES - CAUSING “B” symptoms
- lymphadenopathy and systemic symptoms caused by REED STERNBERG CELL release of CYTOKINES (include symptoms like fever, chills, wt. loss, night sweats).
- cytokines attract lymphocyte, plasma cells, Macs and eosinophils (makes up the BULK of the tumor) -
RSC these are large multi lobed cells. Two halves are often mirror images of each other and look like “owl’s eyes.”
- RS cells are usually CD15 And CD30 positive!
- attract reactive lymphocytes, plasma cells, macrophages and eosinophils - may lead to FIBROSIS
(Note: although RS cells are in Hodgkin Lymphoma, they can also be seen in other disorders)
The malignant cell in Hodgkin Lymphoma is the Reed Sternberg cell. The cell is actually a minority in the cells that make up the enlarged lymph node. (only about 1-5%). The bulk of the cells are reacting to the presence of the RS cell’s release of large cytokines. If you remember, RS cells release lots of cytokines too. This can help you to remember that B symptoms are more common in Hodgkin lymphoma than in nonhodgkin lymphoma.
In addition, HL may lead to hyper-CALCEMIA. Why?
- b/c one of the reactive cell types are MACROPHAGES which have 1-ALPHA-HYDROXYLASE, and enzyme which converts 25-OH-VIT-D to 1,25-OH-VIT D
Risk Factors: - prior EBV infection (virus infects B cells)
- immunosuppresants
- autoimmune diseases (RA, SLE)
Treatment: chemotherapy and radiation therapy, BLEOMYCIN
4 types:
- Nodular sclerosing - most common (70%)
Classical Presentation: - enlarging CERVICAL neck or MEDIASTINAL LN in a YOUNG adult (usually FEMALE)
Lab Findings: - LACUNAR VARIANT REEDSTERNBERG cells seen in clear LAKE-LIKE spaces
- Fibrous tissue surrounds a portion of tumor, creating nodules (NS type get its name because of this)
Prognosis: - Slow growth –> indolent - GOOD long term survival for the patient
- Mixed Cellularity - associated with abundance of EOSINOPHILS (called in by IL-5 which is produced by _REEDSTERNBERG cells) - will also see eosinophils, neutrophils, macrophages, plasma cells
- Lymphocyte Rich: - GOOD prognosis
- Lymphocyte poor ; - BAD PROgnosis
Marginal Zone Lymphoma
- neoplastic proliferation of __ __ ___ (CD20) that expands that ___ zone
- associated with chronic ___ (e.g. ___, ____, ____) -
B-cell malignancy that is adjacent to the ___ cells (___ zone is next to mantle cells which are next to ___)
- Most lymph nodes don’t have a ____ zone. The zone is formed only when there is activation of the cells through the germinal center. So, when cells go to the germinal cells and get activated (b/c of chronic inflammation), that is when the marginal zone is produced.
So, the MZL is classically seen in ___ inflammatory states such as in:
- __ ___ in Sjogren’s
- ____gland in Hashimoto
- ____ stomach infections –> MALToma (MALToma’s are a form of marginal zone lymphomas
Epidemiology - affects____
Genetics: - t(___;____)
Marginal Zone Lymphoma
- neoplastic proliferation of small B cellv(CD20) that expands that mantle zone
- associated with chronic inflammation (e.g. Sjogrens, IBS, MALTomas) -
B-cell malignancy that is adjacent to the mantle cells (marginal zone is next to mantle cells which are next to follicles)
- Most lymph nodes don’t have a marginal zone. The zone is formed only when there is activation of the cells through the germinal center. So, when cells go to the germinal cells and get activated (b/c of chronic inflammation), that is when the marginal zone is produced.
So, the MZL is classically seen in chronic inflammatory states such as in:
- salivary glands in Sjogren’s
- thyroid gland in Hashimoto
- h pylori stomach infections –> MALToma (MALToma’s are a form of marginal zone lymphomas
Epidemiology - affects adults
Genetics: - t(11:18)
Mantle Cell Lymphoma
- VERY ___
- neoplastic __ __ cells (CD20) that expand the ___ zone (mantle cell is immediately adjacent to the follicle)
- arises from follicle ___ or sometimes ___ cells.
Epidemiology: - Affects adult ___ (males __ females)
Median Overall Survival - __ to __ years (___ prognosis)
Markers: CD___ and CD___ (and CD19) - like SLL and CLL!
Genetics: - ___:___ translocations (__ to __%) - Do you remember what was on Cr. 14? —> ___ ___!! -
What gets translocated there? —> ____!
What does over expression of ___ do? –> _____ the regulators which makes the cell cycle to go from ___ to ___ facilitating neoplastic proliferation.
Mantle Cell Lymphoma
- VERY AGGRESSIVE
- neoplastic SMALL B cells (CD20) that expand the MANTLE zone (mantle cell is immediately adjacent to the follicle)
- arises from follicle MANTLE or sometimes GERMINAL cells.
Epidemiology: - Affects adult MALES (males >females)
Median Overall Survival - 3 to 4 years (POOR prognosis)
Markers: CD5 and CD20 (and CD19) - like SLL and CLL!
Genetics: - 11;14 translocations (30 to 40%) - Do you remember what was on Cr. 14? —> IMMUNOGLOBULIN HEAVY CHAIN!! -
What gets translocated there? —> CYCLIN D!
What does over expression of CYCLIN D do? –> PHOSPHORYLATES the regulators which makes the cell cycle to go from G1 to S facilitating neoplastic proliferation.
T cell Leukemia/Lymphoma
- neoplastic proliferation of mature ____+ T cells
- Occurs with ____-__ infection
- RNA virus - Infects ___+ T cells
Epidemiology: - endemic in___, ___ and ___.
Presentation:
- ____
- _____
- _____
- ___ ____ (ulcers, nodules, papular rash)
- Rapidly ___ symptoms –> fatal within months!
- If you see “__ ___ LESIONS WITH HIGH ___ LEVELS” on an exam, don’t jump to __ __.
Remember, TCL will also presents the same way, except TCL its also have a ____!!!!!
Lab Findings: - key diagnostic test: ____ antibodies
Note: Patients with ___ ___ also have lytic bone lesions with high ___ levels. Do not confused this though with T cell Leukemia/Lymphoma. MM patients DO NOT have __ __, or __ __ and no ___
T cell Leukemia/Lymphoma
- neoplastic proliferation of mature CD4+ T cells
- Occurs with HTLV-1 infection
- RNA virus - Infects CD4+ T cells
Epidemiology: - endemic in JAPAN, CARRIBEAN and W. AFRICA
Presentation:
- LYMPHADENOPATHY
- LYMPHOCYTOSIS
- HEPATOSPLENOMEGALY
- SKIN LESIONS (ulcers, nodules, papular rash)
- Rapidly PROGRESSIVE symptoms –> fatal within months!
- If you see “LYTIC BONE LESIONS WITH HIGH CALCIUM LEVELS” on an exam, don’t jump to MULTIPLE MYELOMA.
Remember, TCL will also presents the same way, except TCL its also have a RASH!!!!!
Lab Findings: - key diagnostic test: ANTI HTLV-1 antibodies
Note: Patients with MM also have lytic bone lesions with high CA2+ levels. Do not confused this though with T cell Leukemia/Lymphoma. MM patients DO NOT have SKIN RASH, or LYMPHADENOPATHY and no LYMPHOCYTOSIS
Cuteaneous T cell Lymphoma
- Skin disorder of malignant T cells.
- Has variable expression of CD markers
- Presents with skin lesions –> but there is a spectrum!
TWO TYPES
- LOCALIZED Disease - ___ ____
- neoplastic proliferation of mature ___4 T cells
Presentation:
- ___, ___ and ___ - all varying in size/shape
- lesions progress ____, changing size/shape and appearance
- ____ –> slowly developing
- Classically, a ___ ___ DISTRIBUTION
Diagnosis:
- Skin biopsy with lymphoid cells
- aggregates of neoplastic cells in the epidermic are called ___ ____ abscesses
2. Diffuse Systemic Disease - ___ ___ - Mycosis Fungiodes can spread to produce ____ Syndrome
- this is a __ __ ____ affecting skin and blood of ___ body
Presentation:
- wide spread ____ (skin is BRIGHT RED)
- _____
Lab Findings
- Malignant cells in blood –> ____ CELLS.
- ___ cells have nuclei that look “___” like
Cuteaneous T cell Lymphoma
- Skin disorder of malignant T cells.
- Has variable expression of CD markers
- Presents with skin lesions –> but there is a spectrum!
TWO TYPES
- LOCALIZED Disease - MYCOSIS FUNGIODIS
- neoplastic proliferation of mature CD4 T cells
Presentation:
- PATCHES, PLAUQES AND TUMORS - all varying in size/shape
- lesions progress SLOWLY, changing size/shape and appearance
- INDOLENT –> slowly developing
- Classically, a BATHING TRUNK DISTRIBUTION
Diagnosis:
- Skin biopsy with lymphoid cells
- aggregates of neoplastic cells in the epidermic are called PAUTRIER abscesses
2. Diffuse Systemic Disease - SEZARY SYNDROME - Mycosis Fungiodes can spread to produce SEZARY Syndrome
- this is a T CELL LYMPHOMA affecting skin and blood of ENTIRE body
Presentation:
- wide spread ERYTHEMA (skin is BRIGHT RED)
- LYMPHADENOPATHY
Lab Findings
- Malignant cells in blood –> SEZARY CELLS.
- SEZARY cells have nuclei that look “CERBRI” like
Multiple Myeloma
- malignancy of ____ cells in __ __
BONE MARRROW > ____% MONOCLONCAL PLASMA CELLS (what is it in MGUS)
- ____ cancer, however, it is the most common malignant lesion of bone overall
- malignancy is HIGHLY DEPENDENT ON ____
Often ___ in MM.
Epidemiology: - affects people > __-___ yo
Lab Diagnostic: - ___ - RBCs form a __ of ___.
This is caused by elevated ____ levels in plasma. This causes RBCs to ___ together.
Causes of MM: __-__ is elevated in MM.
__-__ is required for ___ cell proliferation.
Excess production causes excess ______ production –> MM symptoms results from excess production of immunoglobulins:
- 55% of cases __ is expressed in excess
- 25% of cases __ is expressed in excess
- 15% of cases __ __ is overexpresssed
When these Ig’s are expressed in excess, we call them ____.
Let’s review what light chains are: 2 types: ___ and ___.
Each antibody has ___ identical light chains. So, an antibody has either have 2___ or 2 ___.
The __ ___ determines the antibody type. For example,___ heavy chain makes an antibody an IgG antibody –> What this means is that antibodies can be described as IgG-k or IgG-lambda.
Under normal circumstances, ___ cells express a slight ___ of __ chains, but these are normally filtered by the ___, and they are reabsorbed in the ___, where they are broken down.
However, in many cases of MM, ____ light chains are produced in excess by plasma cells, and when excess light chains are produced in MM, this leads to a special pathologies and symptoms that is part of the disorder:
Pathologies and Symptoms:
- ____ Damage and Proteinuria –> ___ chains are toxic to kidneys and cause __ damage –> known as “____ kidney”
Why does renal failure happen? - this occurs because small amounts of light chains normally are filtered/reabsorbed by the PCT.
In the setting of MM, if ___ light chain is produced and ___ capacity is ____. - this means that the light chains then go to the __. There, it is combined with a protein called “__ __ __ ___ (THM).
- THM and light chains combine and form obstructing “casts,” which ___ urine flow through the nephron. This causes __ __.
In addition, some light chains get excreted into the __. When light chains are found in urine, they are called __ __ protein. ___ also contributes to renal failure. In fact, __ of ANY cause can cause renal failure. This is b/c high Ca++ levels impair the renal ability to concentrate the urine. When the kidneys can’t concentrated, they produce excess urine that is dilute –> this leads to ____ and volume contraction. This lowers ___ and causes renal failure.
Tests: Dipstick will be ____ for protein when light chain (LC) is in urine. That is b/c dipsticks can detect ____ but is poor at detecting LCs. For this reason, ___ is used – which is similar to SPEP. A positive UPEP test indicates the presence of LCs in urine.
When LCs are in the urine they are called __ __ PROTEIN.
- __ pain with hypercalcemia –> neoplastic plasma cells activated ____ receptors on osteoclasts. As a result, lytic ‘__ __’ lesions are seen on x ray, especially in the __ and ___ –> increased risk of ___!
- Elevated serum ___ –> neoplastic plasma cells produce ___. _______ is present on SPEP and is most commonly due to __ and __.
- Increased risk for ___ –> monoclonal antibody lacks antigenic diversity; infection is the most common cause o death in MM!
Recurrent bacterial infections are commonly caused by: S. ___ S. ___ and E. Coli
- Anemia - MM also leads to a ____, ____ anemia. - Etiology is multifactorial
- Bone marrow is often replaced by malignant _____ cells. This leads to ___ production of RBCs. - Additionally,__ __ causes low EPO levels, which also causes anemia
- Weakness and pallor often present at diagnosis - Primarly ___ - free light chains circulate th serum and deposit in tissues
Common way it is presented: - Elderly patient has a mild fall, and fractures their vertebral columns. A work up is done and identifies the MM.
____ is also seen due to bone resorption –> much higher serum calcium In addition, excess light chains can cause a type of ___that deposits into tissues called AL ____. There is a special test used to identify the excess Its that occurs in MM. It is called the SPEP –> serum protein electrophoresis
Numerous plasma cells with __-face chromatin and intracytoplasmic inclusions containg __ can be seen.
When you think of MM, think “MMM CRABB!”
What does it stand for?.
Multiple Myeloma
- malignancy of plasma cells in BM
BONE MARRROW > 10% MONOCLONCAL PLASMA CELLS (In MGUS < 10%)
- METASTATIC cancer, however, it is the most common malignant lesion of bone overall
- malignancy is HIGHLY DEPENDENT ON IL-6
Often OVEREXPRESSED in MM.
Epidemiology: - affects people > 40-50 yo
Lab Diagnostic: - ROULEUX - RBCs form a STACK of COINS
This is caused by elevated PROTEIN levels in plasma. This causes RBCs to STICK together.
Causes of MM: IL-6 is elevated in MM.
IL-6 is required for PLASMA cell proliferation.
Excess production causes excess PLASMA production –> MM symptoms results from excess production of immunoglobulins:
- 55% of cases IgG is expressed in excess
- 25% of cases IgA is expressed in excess
- 15% of cases light chain is overexpresssed
When these Ig’s are expressed in excess, we call them PARAPROTENS.
Let’s review what light chains are: 2 types: KAPPA and LAMBDA
Each antibody has 2 identical light chains. So, an antibody has either have 2 KAPPA or 2 LAMBDA
The HEAVY CHAIN determines the antibody type. For example,G heavy chain makes an antibody an IgG antibody –> What this means is that antibodies can be described as IgG-k or IgG-lambda.
Under normal circumstances, PLASMA cells express a slight EXCESS of LIGHT chains, but these are normally filtered by the GLOMERULUS, and they are reabsorbed in the PCT, where they are broken down.
However, in many cases of MM, EXCESS light chains are produced in excess by plasma cells, and when excess light chains are produced in MM, this leads to a special pathologies and symptoms that is part of the disorder:
Pathologies and Symptoms:
1.RENAL Damage and Proteinuria –> LIGHT chains are toxic to kidneys and cause RENAL damage –> known as “MYELOMA kidney”
Why does renal failure happen? - this occurs because small amounts of light chains normally are filtered/reabsorbed by the PCT.
In the setting of MM, if EXCESS light chain is produced and PCT capacity is EXCEEDED. - this means that the light chains then go to the DCT. There, it is combined with a protein called “TAM HORSEFALL MUCO PROTEIN (THM).
- THM and light chains combine and form obstructing “casts,” which OBSTRUCT urine flow through the nephron. This causes RENAL DAMAGE
In addition, some light chains get excreted into the URINE. When light chains are found in urine, they are called BENCE JONE protein. HYPERCALCEMIA also contributes to renal failure. In fact, HYPERCALCEMIA of ANY cause can cause renal failure. This is b/c high Ca++ levels impair the renal ability to concentrate the urine. When the kidneys can’t concentrated, they produce excess urine that is dilute –> this leads to POLYUREA and volume contraction. This lowers GFR and causes renal failure.
Tests: Dipstick will be NEGATIVE for protein when light chain (LC) is in urine. That is b/c dipsticks can detect ALBUMIN but is poor at detecting LCs. For this reason, UPEP is used – which is similar to SPEP. A positive UPEP test indicates the presence of LCs in urine.
When LCs are in the urine they are called BENCE JONE PROTEIN.
- BONE pain with hypercalcemia –> neoplastic plasma cells activated RANK receptors on osteoclasts. As a result, lytic ‘PUNCHED OUT’ lesions are seen on x ray, especially in the VERTEBRAE and SKULL –> increased risk of FRACTURES!
- Elevated serum PROTEIN –> neoplastic plasma cells produce IG. M SPIKE is present on SPEP and is most commonly due to IGG and IGA
- Increased risk for INFECTIONS –> monoclonal antibody lacks antigenic diversity; infection is the most common cause o death in MM!
Recurrent bacterial infections are commonly caused by: S. PNEUMO, S. AUREUS and E. Coli
- Anemia - MM also leads to a NORMOCYTIC, NORMOCHROMIC anemia. - Etiology is multifactorial
- Bone marrow is often replaced by malignant PLASMA cells. This leads to DECREASED production of RBCs. - Additionally,RENAL DAMAGE causes low EPO levels, which also causes anemia
- Weakness and pallor often present at diagnosis - Primarly AMYLOIDOSIS - free light chains circulate th serum and deposit in tissues
Common way it is presented: - Elderly patient has a mild fall, and fractures their vertebral columns. A work up is done and identifies the MM.
HYPERCALCEMIA is also seen due to bone resorption –> much higher serum calcium In addition, excess light chains can cause a type of AMYLOIDOSIS that deposits into tissues called AL (AMYLOID LIGHT CHAIN) AMYLOIDOSIS. There is a special test used to identify the excess Its that occurs in MM. It is called the SPEP –> serum protein electrophoresis
Numerous plasma cells with CLOCK-face chromatin and intracytoplasmic inclusions containg IG can be seen.
When you think of MM, think MMM, CRABB!. What does it stand for?
MM, MONOCLONAL, M PROTEIN
HYPERCALCEMIA
RENAL INSUFFICIENCY
ANEMIA
BONE LYTIC LESIONS, BACK PAIN
MGUS - monoclonal gammopathy of undetermined significance
- ___ seen on SPEP, but other features of multiple myeloma are absent
- common in ___ (seen in ___% of 70 y/o’s)
- ___% of these patients will end up developing MM.
So, lets say you see a patient with increased serum protein with M spike on SPEP. But then, you don’t see a lytic lesions, hypercalcemia, amyloid, OR Bence-Jones Proteinuria…what is going on with this ISOLATED M SPIKE?
This is called MGUS - monoclonal gammopathy of undetermined significance - asymptomatic plasma cell disorder
- Pts with MGUS have abnormal SPEP (presence of M protein)
- NO ___ ____ DAMAGE, however CAN PROGRESS TO ____.
- Often times, MGUS is detected during a work up of another problem such as: anemia, hyper-____and ____ pain.
no CRABB symptoms.
MGUS - monoclonal gammopathy of undetermined significance
- M SPIKE seen on SPEP, but other features of multiple myeloma are absent
- common in ELDERY (seen in 5% of 70 y/o’s)
- 1% of these patients will end up developing MM.
So, lets say you see a patient with increased serum protein with M spike on SPEP. But then, you don’t see a lytic lesions, hypercalcemia, amyloid, OR Bence-Jones Proteinuria…what is going on with this ISOLATED M SPIKE?
This is called MGUS - monoclonal gammopathy of undetermined significance - asymptomatic plasma cell disorder
- Pts with MGUS have abnormal SPEP (presence of M protein)
- NO END ORGAN DAMAGE, however CAN PROGRESS TO MM (1%)
- Often times, MGUS is detected during a work up of another problem such as: anemia, hyper-calcemia and bone pain.
no CRABB symptoms.
WM WALDERNSTRONG MACROBLOBINEMIA
- must be distinguished from MGUS.
- __ ___ lymphoma with __ ___ production
- M spike = Ig___ (flip the W upside down!)
- hyper____ syndrome (e.g. ____ vision, ____ phenomenon - a condition in which some areas of the body feel numb and cool in certain circumstances.)
- no MM findings (No CRABB findings)
WM WALDERNSTRONG MACROBLOBINEMIA
- must be distinguished from MGUS.
- B CELL lymphoma with MONOCLONAL IGM production
- M spike = IgM
- hyperVISCOSITY syndrome (e.g. BLURRED vision, RAYNAUD phenomenon - a condition in which some areas of the body feel numb and cool in certain circumstances.)
- no MM findings (No CRABB findings)
Langerhans Cell Histiocytosis
- neoplastic proliferation of __ cells
- special __ cells found on skin
- derived from ___ of __ ___
- – cells are funtionally ____ and do not effectively ___ primary T cells via ___ presentation.
- recurrent ___ ___with a mass involving the __ __
Lab Findings: - characteristic ___(TENNIS RACKET) granules seen on EM
Markers: - __ and ___ and ___ by immunohistochemistry
Key Pearls: - IF THE DISEASE IS NAMED AFTER SOMEONE, IT IS USUALLY MALIGNANT. - IF IT IS MALIGNANT, IT WILL INVOLVE THE SKIN - IF THE DISEASE HAS TWO NAMES IN IT: IT AFFECTS CHILDREN < 2. - IF IT HAS THREE NAMES, IT AFFECTS CHILDREN > 3
Hand-Schuller-Christian Disease -
- proliferation of LCs.
Epidemiology: - affects children > ___
Presentation: - “SSLED”
Prognosis: ____
Eosinophilic granuloma
- common in _____
- benign proliferation of DC cells in BM
Presentation - pathologic ___ in adolescent
is the skin invovled?
- pathological ___ __ but no ____
- biopsy shows LCs with mixed ____ ceLls, including ___
Prognosis - ___
Letterer-Siwe
____ proliferation of LCs
Epidemiology: - infants <__ y/o)
Presentation: - is there a ski rash?
lesions
- diffuse __
Prognosis - ____
- cystic _____ defects in infant (infant < __ years old)
- multiple organs may be invovled- cystic bone
Langerhans Cell Histiocytosis
- neoplastic proliferation of DC cells
- special DC found on skin
- derived from MONOCYTES OF BM
- – cells are funtionally IMMMATURE and do not effectively STIMULATE primary T cells via ANTIGEN presentation.
- recurrent OTITIS MEDIA with a mass involving the MASTOID BONE
Lab Findings: - characteristic BIRBECK (TENNIS RACKET) granules seen on EM
Markers: - C1a and S100 and CD207 by immunohistochemistry
Key Pearls: - IF THE DISEASE IS NAMED AFTER SOMEONE, IT IS USUALLY MALIGNANT. - IF IT IS MALIGNANT, IT WILL INVOLVE THE SKIN - IF THE DISEASE HAS TWO NAMES IN IT: IT AFFECTS CHILDREN < 2. - IF IT HAS THREE NAMES, IT AFFECTS CHILDREN > 3
Hand-Schuller-Christian Disease -
- proliferation of LCs.
Epidemiology: - affects children > 3
Presentation: - “SSLED”
scap rash
skin rash
lytic bone defects
- exopthalmos in children
diabetes insipidus
Prognosis: BAD
- *Eosinophilic granuloma
- common in adolescents**
- benign proliferation of DC cells in BM
Presentation - pathologic fracture in adolescent
-SKIN is not involved - NO SKIN RASH
- pathological bone fracture but no osteosarcoma
- biopsy shows LCs with mixed INFLAMMATORY ceLls, including EOSINOPHILS
Prognosis - GOOD
Letterer-Siwe
MALIGNANT proliferation of LCs
Epidemiology: - infants <2 y/o)
Presentation: - skin RASH
lesions
- diffuse rash
Prognosis - pOOR
- cystic SKELETAL defects in infant (infant < 2 years old)
- multiple organs may be invovled- cystic bone
Anaplastic Large Cell Lymphoma (ALCA)
Presentation: - ___/___ skin, bone, soft tissue, lung liver)
Epidemiology ___ and ____adults __>>___
Advanced stage with __ ____ (fever, night sweats, weight loss)
____ CLINICAL COURSE
Lab Findings: -___ infiltrate - “______” cells
Markers: CD___, CD___ (STRONG), ALK-1 PROTEINS
Genotype: t(__;___)
- ALK + cases > 80% survival
Anaplastic Large Cell Lymphoma (ALCA)
Presentation: - nodal/extranodal (skin, bone, soft tissue, lung liver)
Epidemiology Children and young adults M>>F
Advanced stage with B symtpoms (fever, night sweats, weight loss)
AGGRESSIVE CLINICAL COURSE
Lab Findings: - sinusoidal infiltrate - “hallmark” cells
Markers: CD3, CD30 (STRONG), ALK-1 PROTEINS
Genotype: t(2;5)
- ALK + cases > 80% survival
For leukemias, it’s usually ___ ____ leukemias that present with massive hepatosplenomegaly because of extramedullary haematopoiesis as the marrow undergoes myelofibrosis.
_____ leukemias don’t typically present with hsp except for __ ____ ___, where there is splenomegaly as the spleen is a lymphoid organ.
For leukemias, it’s usually chronic myeloid leukemias that present with massive hepatosplenomegaly because of extramedullary haematopoiesis as the marrow undergoes myelofibrosis.
Acute leukemias don’t typically present with hsp except for acute lymphoblastic leukemia, where there is splenomegaly as the spleen is a lymphoid organ.
Tdt is a marker for what?
immature lymphoblasts
would you see a tdt marker for a mature lymphocyte?
no..only for immature lymphoblast


